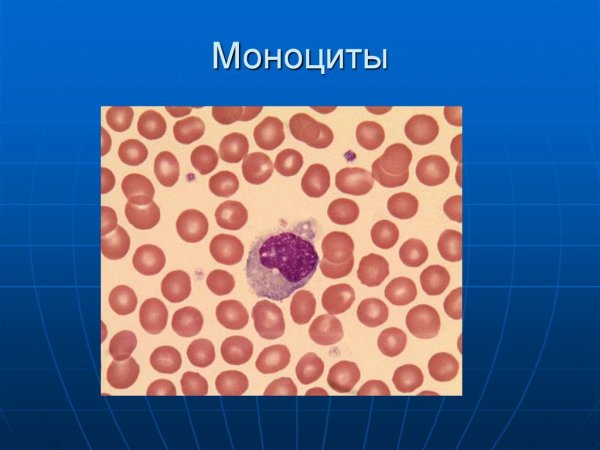
Разновидности моноцитов
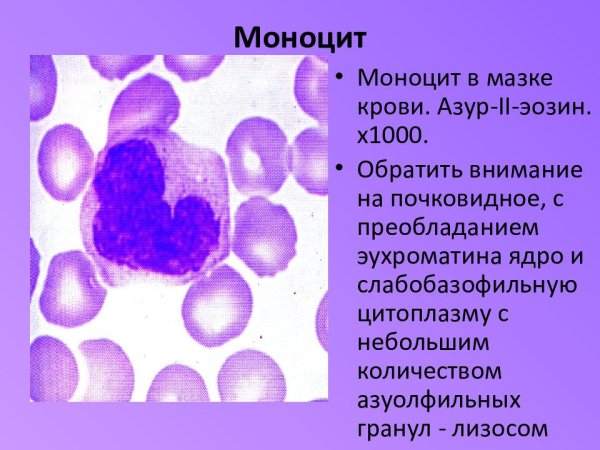
Моноциты строение
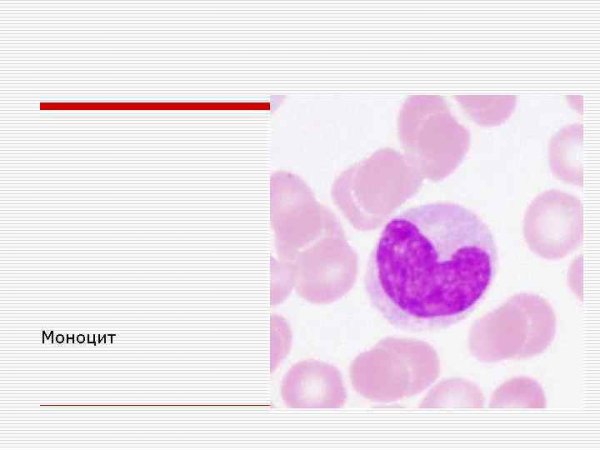
Моноциты строение
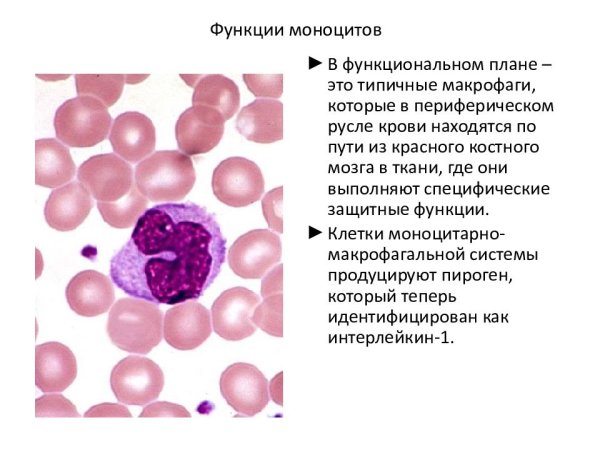
Характерное строение моноцитов
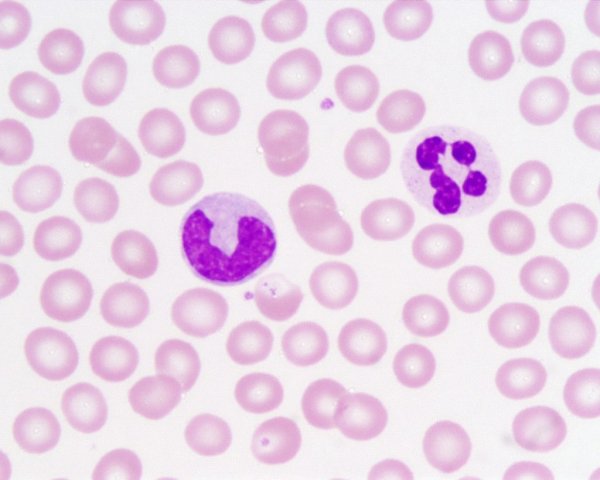
Палочкоядерные нейтрофилы мазок

Моноцит рисунок - это уникальное художественное произведение, выполненное в монотонной гамме, которое привлекает внимание своей оригинальностью и выразительностью. Различные оттенки серого и черного создают особую атмосферу и передают настроение автора. Моноцит рисунок может быть выполнен различными материалами, такими как уголь, графит или тушь, что позволяет достичь разных эффектов и текстур. Этот вид искусства привлекает взгляд зрителя и заставляет задуматься о глубине и смысле произведения. Моноцит рисунок является прекрасным способом самовыражения и передачи эмоций, который может стать ярким украшением интерьера или частью коллекции искусство-любителя.
Клетка моноциты под микроскопом
Характерное строение моноцитов
Разновидности моноцитов
Моноциты строение
Характерное строение моноцитов
Моноциты строение
Клетка моноциты под микроскопом
Моноцит рисунок гистология
Строение моноцитов гистология
Моноциты и лимфоциты рисунок
Моноциты строение
Моноциты в мазке крови
Лимфоцит рисунок
Моноциты строение и функции
Морфология клеток крови моноцит
Моноцит Гиста
Моноциты клетки
Строение моноцитов гистология
Схема ультрамикроскопического строения моноцита
Моноцит строение клетки
Моноциты микроскопия
Моноциты строение
Моноциты строение
Моноциты с рассеченными ядрами
Характерное строение моноцитов
Моноциты картинки
Моноциты строение
Характерное строение моноцитов
Моноциты иммунология
Клетки крови моноциты лимфоциты гранулоциты
Моноцит строение клетки
Палочкоядерные нейтрофилы мазок
Лейкоциты мазок крови человека гистология
Лейкоциты гистология строение
Моноцит гиф
Монобласты и промоноциты
Лимфоциты моноциты гранулоциты
Моноциты строение и функции
Макрофаг на белом фоне
Строение моноцитов гистология
Гистоцит и моноцит рисунок
Лейкоциты эозинофилы базофилы нейтрофилы
Разновидности лейкоцитов
Моноциты картинки
Эозинофилы в лейкоцитарной формуле
Нейтрофилы эозинофилы лимфоциты
Лимфоцит рисунок
Лейкоциты гранулоциты и агранулоциты
Смотрите онлайн или можете скачать на телефон или компьютер в хорошем качестве совешенно бесплатно. Не забывайте оставить комментарий и посмотреть другие фотографии и изображения высокого качества, например солнцепек рисунок и неджи рисунок из раздела Рисунки

Grizly.club
Grizly.club